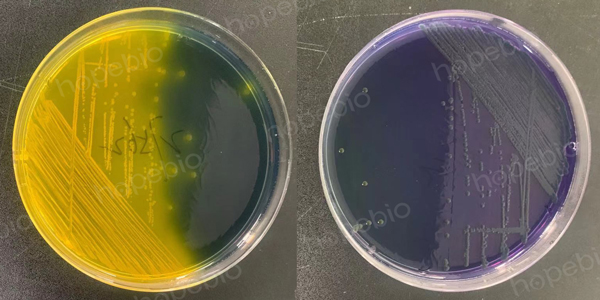

海博微信公众号
海博天猫旗舰店




一、用途及原理
该培养基用于创伤弧菌的选择性分离培养。
蛋白胨、䏡胨提供细菌生长的基本营养,稍高含量的氯化钠、氯化镁和氯化钾提供与海水相近的渗透压,有利于弧菌的生长,溴麝香草酚蓝和甲酚红为酸碱指示剂,酸性条件下均显黄色,溴麝香草酚蓝碱性条件下显蓝色,甲酚红碱性条件下显紫红色,纤维二糖为可发酵碳源,较高浓度的多粘菌素B和多粘菌素E可抑制大多数革兰氏阴性菌的生长。
创伤弧菌可在此培养基中生长,分解纤维二糖产酸,菌落呈黄色,菌落周围因产酸也变为黄色。其他不能利用纤维二糖的弧菌,菌落通常呈蓝绿色至紫红色。
二、培养基配方(g/L)
|
蛋白胨 |
10.0 |
|
月示胨 |
5.0 |
|
氯化钠 |
10.0 |
|
六水氯化镁 |
4.0 |
|
氯化钾 |
4.0 |
|
溴麝香草酚蓝 |
0.04 |
|
甲酚红 |
0.04 |
|
琼脂 |
15.0 |
|
纤维二糖 |
15.0 |
|
多粘菌素B |
40万IU |
|
多粘菌素E |
100万IU |
|
pH |
7.6±0.1 |
三、使用方法
称取本品45.95g,加热煮沸溶解于900ml蒸馏水中,分装,每瓶90mL,冷却至48-55℃左右时,每90mL培养基中加入无菌10%纤维二糖溶液15mL和1支CPC琼脂添加剂(多粘菌素B40000IU、多粘菌素E100000IU),混匀,倾入无菌平皿,备用。
四、生长现象
接种以下质控菌株,在36±1℃下培养18-24小时:
|
质控菌株 |
菌株编号 |
生长情况 |
其他特征 |
|
创伤弧菌 |
ATCC27562 |
+ |
黄色菌落,周围变黄 |
|
霍乱弧菌 |
CICC23794 |
+ |
蓝绿色至紫色菌落,周围变紫 |
|
大肠埃希氏菌 |
ATCC25922 |
- |
抑制 |
创伤弧菌ATCC27562
霍乱弧菌CICC23794
相关产品:
注:本文属海博生物原创,未经允许不得转载。
上一篇:乳糖肉汤培养基的原理和使用方法
| 相关文章: | ||
